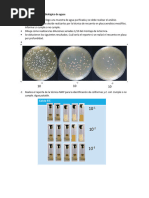

0% encontró este documento útil (0 votos)
266 vistas3 páginasEvaluación Eficaz de Desinfectantes
Este documento describe una práctica de laboratorio para analizar la eficacia de un desinfectante en superficies mediante el uso de placas RODAC y hisopos. El objetivo es determinar la concentración de desinfectante necesaria para eliminar microorganismos en superficies de trabajo y objetos no planos. El procedimiento incluye la preparación de medios de cultivo, la toma de muestras antes y después del tratamiento con desinfectante, el análisis e interpretación de los resultados obtenidos.
Cargado por
Alejandra OchoaDerechos de autor
© © All Rights Reserved
Nos tomamos en serio los derechos de los contenidos. Si sospechas que se trata de tu contenido, reclámalo aquí.
Formatos disponibles
Descarga como PDF, TXT o lee en línea desde Scribd
0% encontró este documento útil (0 votos)
266 vistas3 páginasEvaluación Eficaz de Desinfectantes
Este documento describe una práctica de laboratorio para analizar la eficacia de un desinfectante en superficies mediante el uso de placas RODAC y hisopos. El objetivo es determinar la concentración de desinfectante necesaria para eliminar microorganismos en superficies de trabajo y objetos no planos. El procedimiento incluye la preparación de medios de cultivo, la toma de muestras antes y después del tratamiento con desinfectante, el análisis e interpretación de los resultados obtenidos.
Cargado por
Alejandra OchoaDerechos de autor
© © All Rights Reserved
Nos tomamos en serio los derechos de los contenidos. Si sospechas que se trata de tu contenido, reclámalo aquí.
Formatos disponibles
Descarga como PDF, TXT o lee en línea desde Scribd